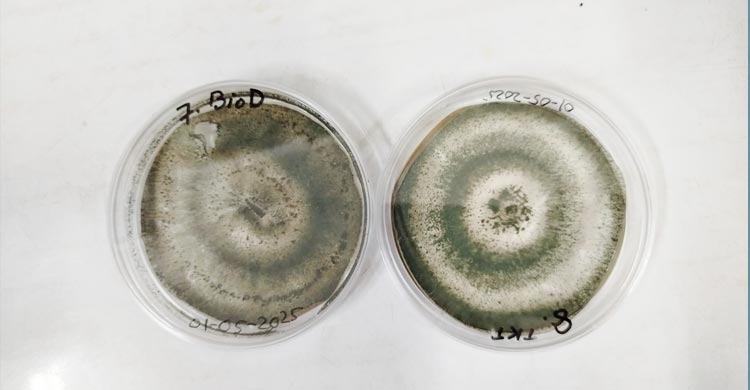
দেশের প্রথম দেশীয় প্রযুক্তির পরিবেশবান্ধব ছত্রাকনাশক উদ্ভাবন

বাকৃবির গবেষণা
দেশে প্রথম দেশীয় প্রযুক্তির পরিবেশবান্ধব ছত্রাকনাশক উদ্ভাবন
দেশে খাদ্য উৎপাদন বাড়লেও বালাইনাশকের অতিরিক্ত ও অনিয়ন্ত্রিত ব্যবহার মানুষের স্বাস্থ্য ও পরিবেশের জন্য হুমকিস্বরূপ হয়ে উঠেছে। এসব বিষাক্ত রাসায়নিক পদার্থ মাটি, পানি এবং বায়ুর মারাত্মক ক্ষতি করছে। বর্তমানে দেশে ব্যবহৃত বালাইনাশকের মধ্যে ছত্রাকনাশকের হার সবচেয়ে বেশি, প্রায় ৪৫-৪৬ শতাংশ। এরপর রয়েছে কীটনাশক ৩৩ শতাংশ এবং আগাছানাশক ২০-২১ শতাংশ। এসব বালাইনাশকের বড় একটি অংশ পরিবেশে ছড়িয়ে পড়ে দূষণ সৃষ্টি করে।
এই পরিস্থিতি মোকাবিলায় বাংলাদেশ কৃষি বিশ্ববিদ্যালয়ের (বাকৃবি) একদল গবেষক সম্পূর্ণ দেশীয় প্রযুক্তি ও উপকারী অনুজীব ব্যবহার করে পরিবেশবান্ধব ছত্রাকনাশক ও ফসল উৎপাদন বৃদ্ধিকারক উদ্ভাবনের দাবি করেছেন।
বিশ্ববিদ্যালয়ের উদ্ভিদ রোগতত্ত্ব বিভাগের অধ্যাপক ড. মোহাম্মদ শাহজাহান মঞ্জিলের নেতৃত্বে একদল গবেষক ‘ট্রাইকোডার্মা এসপেরেলাম’ নামে উপকারী ছত্রাক ব্যবহার করে একটি নতুন পরিবেশবান্ধব ছত্রাকনাশক উদ্ভাবন করেছেন, যার নাম ‘পি.জি. ট্রাইকোডার্মা’। অধ্যাপক মঞ্জিল নিজেই এই ছত্রাক আইসোলেট করেন এবং এর বায়োফর্মুলেশন উন্নয়ন করেন।
গবেষক দলের সদস্য কৃষি রসায়ন বিভাগের অধ্যাপক ড. কে এম মহিউদ্দিন ছত্রাকনাশকটির গুণগত মান ও কার্যকারিতা বাড়াতে কাজ করেন। অন্যদিকে, এর উৎপাদন প্রক্রিয়া ও পরিবেশগত দিকগুলো মূল্যায়ন করেন ফার্ম স্ট্রাকচার ও এনভায়রনমেন্টাল ইঞ্জিনিয়ারিং বিভাগের অধ্যাপক ড. মো. আলী আশরাফ। পুরো গবেষণাটি বাকৃবির মাইক্রোবায়োলজি ও বায়োকন্ট্রোল ল্যাবরেটরিতে পরিচালিত হয়।
পরিবেশবান্ধব এই ছত্রাকনাশক সম্পর্কে গবেষক দলের প্রধান অধ্যাপক ড. মোহাম্মদ শাহজাহান মঞ্জিল বলেন, ছত্রাকনাশকটির মূল উপাদান ট্রাইকোডার্মা এস্পেরেলাম যা, আমাদের দেশের মাটি থেকে গবেষণার মাধ্যমে শনাক্ত ও আলাদা করা হয়েছে। অর্থাৎ এটি সম্পূর্ণ স্থানীয় উৎস থেকে সংগ্রহ করা এবং বাংলাদেশের জলবায়ুতে অনুজীবটি ভালোভাবে অভিযোজিত।
তিনি বলেন, গবেষণার শুরুতে দেশের বিভিন্ন কৃষি পরিবেশ অঞ্চল থেকে কয়েক হাজার মাটি ও রাইজোস্ফিয়ারের (শিকড়ঘেঁষা) মাটির নমুনা সংগ্রহ করে শতাধিক ট্রাইকোডার্মা ছত্রাক পৃথক করা হয়েছে। ট্রাইকোডার্মার শতাধিক প্রজাতি থাকলেও আমরা ট্রাইকোডার্মা এস্পেরেলাম বেছে নিয়েছি। কারণ এটি আমাদের দেশের পরিবেশের সঙ্গে সবচেয়ে ভালোভাবে অভিযোজিত এবং অধিক কার্যকর। এছাড়া দেশীয় অণুজীব থেকে এই ছত্রাকনাশকটির উন্নয়ন করা হয়েছে বিধায় বাজারে প্রাপ্ত অন্যান্য আমদানিকৃত ট্রাইকোডার্মার চেয়ে এটি বেশি কার্যকর।
অধ্যাপক মহিউদ্দিন জানান, ছত্রাকনাশকটি জৈবসার হিসেবেও কাজ করার কারণে মাঠ পর্যায়ের পরীক্ষায় দেখা গেছে, ফসল উৎপাদনে রাসায়নিক সার প্রায় ২০-২৫ শতাংশ কম ব্যবহার করেও প্রায় একই বা বেশি ফলন পাওয়া সম্ভব হয়েছে।
পি.জি. ট্রাইকোডার্মা ব্যবহারে ফসল উৎপাদন বৃদ্ধি প্রসঙ্গে অধ্যাপক শাহজাহান মঞ্জিল বলেন, ছত্রাকনাশকটির প্রয়োগে আমরা ছত্রাকজনিত রোগ প্রতিরোধের পাশাপাশি বিভিন্ন ফসলের উল্লেখযোগ্য ফলন বৃদ্ধি লক্ষ্য করেছি। টমেটো, আলু ও বেগুনে ফলন বৃদ্ধি পেয়েছে প্রায় ২০-২৫ শতাংশ, পালং ও পুঁইশাকে ফলন বেড়েছে ৪০-৫০ শতাংশ, পানে ফলন বেড়েছে প্রায় ৪৫-৫০ শতাংশ, চা গাছে ফলন বৃদ্ধি পেয়েছে ৮০-১০০ শতাংশ, ঢ্যাঁড়শ, মরিচ ও শসায় ফলন বেড়েছে ১৫-২০ শতাংশ। ডাল, ধান ও ফলগাছে রোগ দমন ও গাছের স্বাস্থ্য ভালো থাকায় ফলন স্থিতিশীল বা ধীরে ধীরে বৃদ্ধির ধারা দেখা যাচ্ছে।
গবেষক দলের প্রধান অধ্যাপক শাহজাহান মঞ্জিল বলেন, পরিবেশবান্ধব ছত্রাকনাশকটি জলজ পরিবেশের জন্যও নিরাপদ। এটি কোনো বিষাক্ত রাসায়নিক উপাদান বহন করে না এবং প্রয়োগের পর পানিতে পড়ে গেলে মাছ, ব্যাঙ, শামুক বা অন্যান্য জলজ প্রাণীর উপর কোনো ক্ষতিকর প্রভাব ফেলে না। আমাদের গবেষণায়ও এ পর্যন্ত জলজ প্রাণীতে কোনো বিরূপ প্রতিক্রিয়া পাওয়া যায়নি।
মৌলভীবাজারের ফুলতলা টি এস্টেটের অ্যাসিস্ট্যান্ট ম্যানেজার শিহাব উদ্দিন চৌধুরী বলেন, ‘আমার চা বাগানে পিজি ট্রাইকোডার্মা ব্যবহার করে আগের চেয়ে দ্বিগুণেরও বেশি ফলন পেয়েছি। আগে যেসব রাসায়নিক ছত্রাকনাশক ও মাইক্রোনিউট্রিয়েন্ট ব্যবহার করতাম, সেগুলোর ব্যবহার অনেকটাই কমিয়ে দিয়েছি।’
নরসিংদীর পানচাষি কৃষিবিদ শফিকুল ইসলাম বলেন, ‘পানচাষে গোড়া পচা মারাত্মক একটি রোগ। এর আক্রমণে গাছ মারা যায়। এই সমস্যা সমাধানে বিভিন্ন রাসায়নিক বালাইনাশক ব্যবহার করতাম। তবে পিজি ট্রাইকোডার্মা ছত্রাকনাশক ব্যবহারের পরে গাছ আর ওই রোগে মারা যায়নি।’
এ বিষয়ে ময়মনসিংহ বিভাগীয় কৃষি অফিসের অতিরিক্ত পরিচালক ড. সালমা লাইজু বলেন, পরিবেশবান্ধব ছত্রাকনাশক উদ্ভাবিত হলে তা মানুষের স্বাস্থ্য, পরিবেশ, গবাদিপশু—সব কিছুর জন্যই উপকারী হবে। এটি দেশের জন্য বিশাল এক সম্ভাবনা হতে পারে।
আসিফ ইকবাল/এসআর/জেআইএম